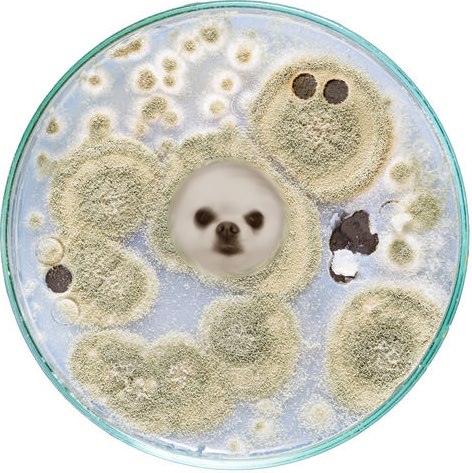

Un Loulou de Poméranie prend son bain |
3 #1 |
|
|---|---|---|
|
Fantôme
|
Pomeranian Sticks Head Out of Bath - 988980
Contribution le : 07/05/2018 19:21
|
|
Signaler |
||
| Quenelski | 4 #2 |
|
|---|---|---|
|
Je masterise !
![]()
Inscrit: 08/11/2013 15:51
Post(s): 2630
Karma: 7942 |
![]()
Contribution le : 07/05/2018 20:58
Edité par Quenelski sur 23/7/2018 6:57:31
|
|
Signaler |
||
| Milot | 2 #3 |
|
|---|---|---|
|
J'aime glander ici
![]()
Inscrit: 31/10/2014 13:06
Post(s): 7023
Karma: 4618 |
Une photo eut suffi !
Contribution le : 07/05/2018 21:33
|
|
Signaler |
||
| Croc63 | 2 #4 |
|
|---|---|---|
|
Je poste trop
![]()
Inscrit: 24/02/2009 13:22
Post(s): 20371
Karma: 12741 |
Vu la quantité de résine qu'il y a, ça a dut au moins mettre deux heures avant de commencer sa prise!
Contribution le : 07/05/2018 22:06
|
|
Signaler |
||
| Smadgib | 7 #5 |
|
|---|---|---|
|
Je suis accro
![]()
Inscrit: 25/03/2018 00:04
Post(s): 1858
Karma: 2296 |
Ça c'est après 6 semaines d'incubation
A 4 jours ça donnait ça ![]()
Contribution le : 08/05/2018 01:47
|
|
Signaler |
||
| Alex333 | 0 #6 |
|
|---|---|---|
|
Je poste trop
![]()
Inscrit: 07/07/2008 12:56
Post(s): 26241
Karma: 13552 |
@Smadgib
Contribution le : 08/05/2018 01:49
|
|
Signaler |
||
| Croc63 | 0 #7 |
|
|---|---|---|
|
Je poste trop
![]()
Inscrit: 24/02/2009 13:22
Post(s): 20371
Karma: 12741 |
Peut être veut il postuler pour jouer le soleil dans les Télégrosseteubbbies?!
Contribution le : 08/05/2018 10:41
|
|
Signaler |
||
| georgette | 2 #8 |
|
|---|---|---|
|
Je m'installe
![]()
Inscrit: 09/01/2005 01:20
Post(s): 403
Karma: 164 |
@Quenelski
Réponse parfaite!
Contribution le : 08/05/2018 11:09
|
|
Signaler |
||
| Quenelski | 1 #9 |
|
|---|---|---|
|
Je masterise !
![]()
Inscrit: 08/11/2013 15:51
Post(s): 2630
Karma: 7942 |
@georgette
Ha quand même un(e) vrai(e) cinéphile ! ![]() ![]()
Contribution le : 08/05/2018 13:04
|
|
Signaler |
||
| thazhok | 0 #10 |
|
|---|---|---|
|
Je masterise !
![]()
Inscrit: 14/04/2015 11:34
Post(s): 3297
Karma: 2390 |
Heu ... la blague est dans le son de la vidéo ?
j'ai pas capté, ya un chien dans l'eau, mais il doit forcement me manquer quelque chose pour percuter. Help ?
Contribution le : 09/05/2018 12:27
|
|
Signaler |
||
0 #11 |
||
|---|---|---|
|
Fantôme
|
@thazhok
c'est une race de chien hydrosoluble
Contribution le : 09/05/2018 16:43
|
|
Signaler |
||

Signaler